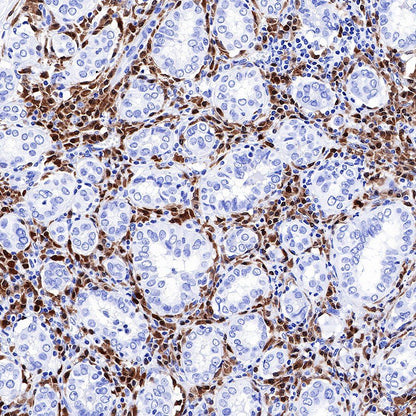

Product Details
Product Details
Product Specification
Host | Rabbit |
Antigen | BOB-1 |
Synonyms | POU2AF1, OBF-1, OCA-B, OCT-binding factor 1 |
Immunogen | Synthetic Peptide |
Location | Nucleus |
Accession | Q16633 |
Clone Number | SDT-263-55 |
Antibody Type | Rabbit mAb |
Application | WB, IHC-P, ICC |
Reactivity | Hu, Ms, Rt |
Purification | Protein A |
Concentration | 0.125 mg/ml |
Physical Appearance | Liquid |
Storage Buffer | PBS, 40% Glycerol, 0.05% BSA, 0.03% Proclin 300 |
Stability & Storage | 12 months from date of receipt / reconstitution, -20 °C as supplied |
Dilution
application | dilution | species |
IHC-P | 1:500 | |
WB | 1:5000 | |
ICC | 1:125 |
Background
BOB-1 interacts with the sequence-specific DNA-binding POU transcription factors (named after the founding family members PIT1, OCT1/2, and UNC86), the ubiquitously expressed OCT1 (POU2F1) and lymphoid-specific OCT2 (POU2F2). As a transcriptional co-activator, BOB-1 itself does not bind DNA but is rather recruited into transcriptional regulation via interaction with DNA-bound POU-domain transcription factors OCT1 and OCT2. The POU-domain is a unique bipartite structure allowing DNA recognition with remarkable flexibility .
Picture
Picture
Western Blot

Immunohistochemistry








Immunocytochemistry

ICC shows positive staining in Ramos cells. Anti-BOB-1 antibody was used at 1/125 dilution (Green) and incubated overnight at 4°C. Goat polyclonal Antibody to Rabbit IgG - H&L (Alexa Fluor® 488) was used as secondary antibody at 1/1000 dilution. The cells were fixed with 4% PFA and permeabilized with 0.1% PBS-Triton X-100. Nuclei were counterstained with DAPI (Blue).

Negative control:ICC shows negative staining in HeLa cells. Anti-BOB-1 antibody was used at 1/125 dilution and incubated overnight at 4°C. Goat polyclonal Antibody to Rabbit IgG - H&L (Alexa Fluor® 488) was used as secondary antibody at 1/1000 dilution. The cells were fixed with 4% PFA and permeabilized with 0.1% PBS-Triton X-100. Nuclei were counterstained with DAPI (Blue).